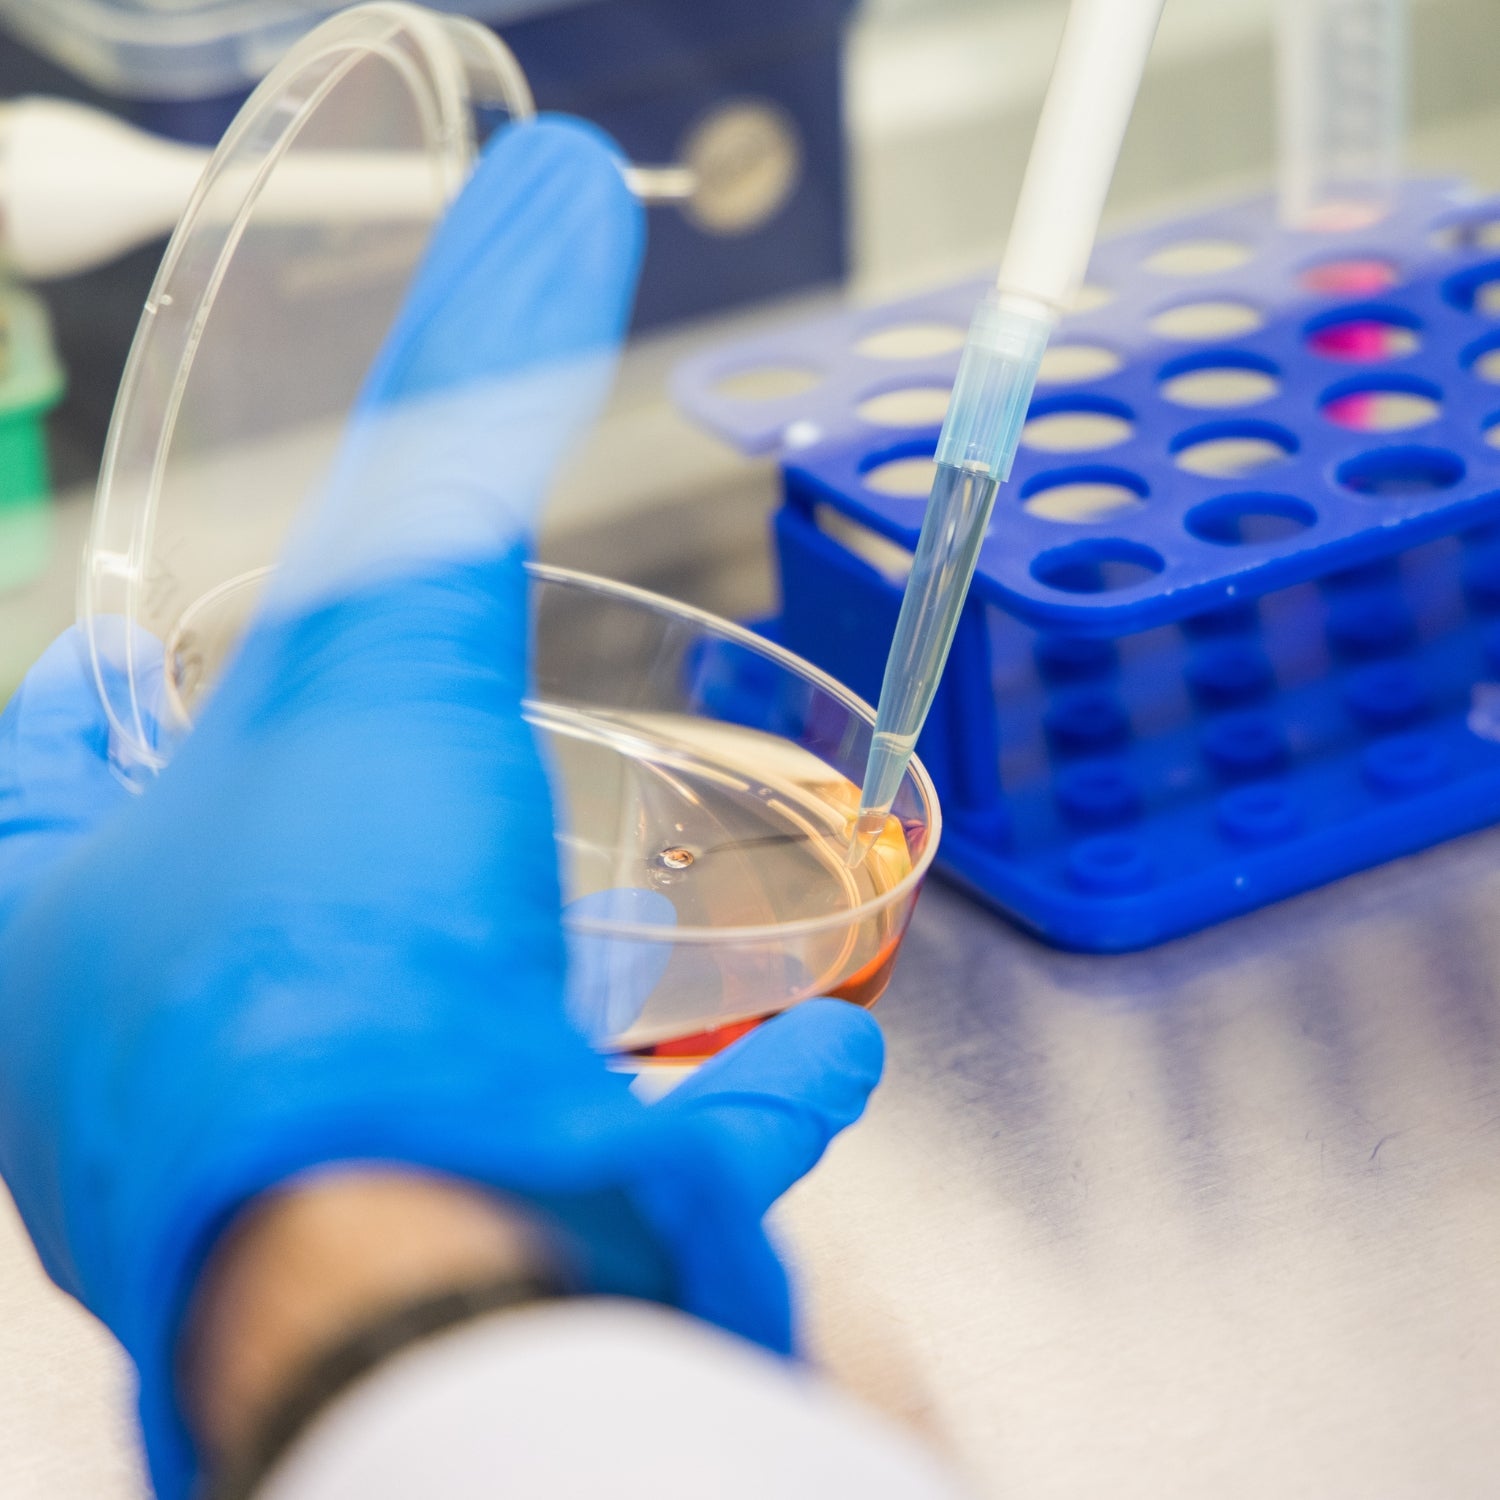
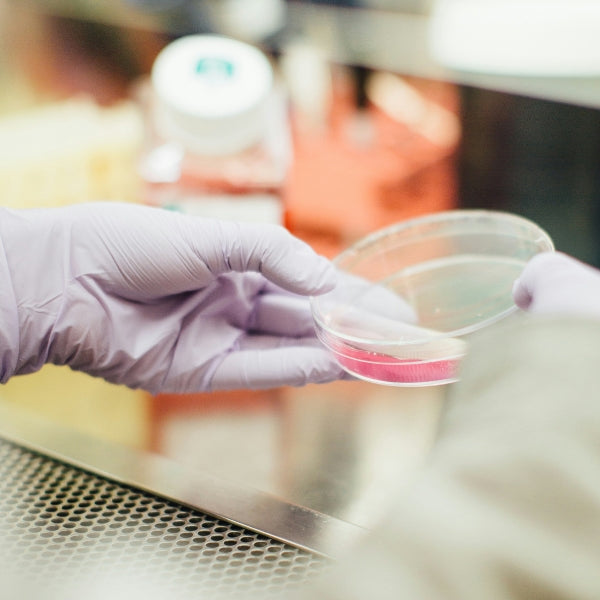

The University of Plymouth

The Brain Tumour Research Centre of Excellence at the University of Plymouth is focused on advancing the development of new treatments for low-grade brain tumours, including glioma, meningioma and schwannoma.
Led by Professor David Parkinson, the Centre is one of Europe’s leading research institutes for low-grade brain tumours. It is working to further our understanding of how these tumours develop and translate that knowledge into life-changing therapies.

Low-grade brain tumours affect thousands of people in the UK every year. These tumours, which include meningioma, glioma and schwannoma, are slow-growing, but cause life-changing symptoms and uncertainty. Despite their significant impact, treatment options are limited. Surgery – the most common treatment method – carries significant risks, especially when tumours are close to nerves or areas that control movement, speech, or balance.
Research at the Centre is paving the way for safer, more effective alternatives, offering hope for a future where treatment is less invasive and outcomes are improved.
How is the Plymouth Centre going to improve outcomes for brain tumour patients?
The programme of work at the Centre is built around three interconnected themes which, together, will support the translation of new therapies from the laboratory into patients. They are working to:
Theme one: Understand tumour biology by investigating how tumours form, grow and evade the immune system
Theme two: Test new treatments by exploring promising medicines and drug combinations through rigorous preclinical studies
Theme three: Build world-class resources by supporting research through the Plymouth Brain Tumour BioBank, a vital resource for advancing discovery
The Centre is also a vibrant hub for training the next generation of brain tumour scientists, ensuring they can continue and expand this research for years to come. Developing talented researchers is essential to sustain progress in brain tumour research and to accelerate the delivery of new treatments to patients. This commitment directly supports the Charity’s research aim to ‘build capacity’
Theme one: Understanding tumour biology
Researchers at the Centre are working to uncover the mechanisms behind how tumours form, grow and evade the immune system. They are also identifying key vulnerabilities in tumours and grouping them by genetic changes - approaches that make it possible to target tumours more effectively with new treatments to stop or slow tumour growth.
-

What triggers glioma tumours to start growing?
Dr Claudia Barros and her team are searching for new molecules that trigger brain tumour growth. By understanding these early changes, they aim to find better ways to stop tumours from forming and developing.
-

How do glioma cells become dormant to evade treatment?
Some glioma cells can hide from treatment and later restart tumour growth. Dr Claudia Barros and her team are looking for ways to stop these cells from going into hiding or waking up again, to make treatments more effective.
-

Could cutting off a meningioma’s energy supply slow its growth?
Dr Leandro Jose de Assis and his team are exploring how aggressive meningioma cells rewire metabolism, including changing the way they generate energy. A key protein, hexokinase 2 (HK2), helps fuel this process.
They aim to block HK2 and its associated partners, potentially slowing tumour cell growth by cutting off its energy supply, while minimising side effects on healthy, non-tumour cells. -

How can we stop brain tumours from hiding from the immune system?
Brain tumours have several ways of hiding from the immune system. They release molecules that help them grow and avoid attack.
Multiple research groups at the Plymouth Centre are working to change that.
Dr Mahmoud Labib’s team is using advanced genomic screening to find and block the genes that control the release of these signals, to develop new treatments. The team is focusing on IL6, which supports blood vessel growth and tumour progression in glioblastoma, and CSF1, which attracts immune cells that protect meningiomas
Meanwhile, Dr Juri Na and Dr Claire Adams are studying how immune cells interact with meningiomas and how radiotherapy might alter these signals. -

Can targeting specific proteins lead to a new treatment for gliomas and other tumour types?
Professor Ming Li and his team are looking at a family of proteins called GBPs which are typically involved in fighting infections and activating the immune system.
The team has already shown that GBPs promote tumour growth by supporting the cells that cause gliomas and by suppressing the immune system around the tumour – two reasons gliomas are hard to treat.
The team is now working to understand how this happens and to develop new treatments targeting GBPs in gliomas, including astrocytoma and glioblastoma, as well as in lower grade tumours such as meningioma and schwannoma. -

How can we make drug treatments work better by overcoming multidrug resistance?
Dr Sylwia Ammoun and her team are collaborating across the Centre to understand how meningioma and schwannoma tumour cells develop resistance to drug and radiation treatments, and how immune cells can actually help these tumours resist therapy.
By targeting this “multidrug resistance” in schwannoma and meningioma tumours, their research could pave the way for better treatments for people living with these tumours
Theme two: Testing new treatments
To accelerate new treatments into the clinic, the team is rigorously testing a range of potential medicines, on their own or in combination with others, to evaluate their effectiveness in tumour samples. Promising candidates will be taken forward into further development, paving the way for clinical evaluation and, ultimately, the creation of new therapies for patients.
-

Could drugs make radiotherapy more effective for meningioma?
Dr Juri Na is leading research into the mechanisms of radio-resistance in meningioma cells, which reduces tumour responsiveness to treatment over time.
To overcome this, Dr Na and her team are exploring the combination of radiotherapy with HDAC inhibitors and other radiosensitisers to boost its effectiveness against aggressive meningioma.
At the same time, the team is screening a comprehensive library of already-approved cancer drugs to find those that could enhance radiotherapy further.
By focusing on approved medicines, this approach could accelerate their translation to the clinic – bring treatments to patients sooner. -

Can new drugs combined with chemotherapy improve treatment for glioma?
Dr Claudia Barros and her team are investigating whether TEAD inhibitors, used alone or alongside chemotherapy, can make treatments more effective for IDH-mutant gliomas.
TEAD proteins play a key role in regulating cell growth and survival, and when this process goes wrong, it can drive tumour progression and resistance to treatment. -

Could MerTK inhibitors offer a non-invasive way to treat meningioma?
Dr Sylwia Ammoun is working with researchers across to the Centre to test repurposed medicines which target MERTK, a protein on the surface of tumour cells, in meningioma and schwannoma, aiming to move to clinical trials in the coming years.
Several MERTK inhibitors are already in trials for other cancer types, offering hope that new treatments could be available soon. -

Can repurposed drugs target ALDH proteins in meningioma and schwannoma?
Prof David Parkinson and his team are studying whether drugs already approved for other conditions can block the activity of ALDH enzymes. These enzymes may play a role in the growth of NF2-related meningioma and schwannoma tumours.
If successful, this approach could offer a new treatment option without the need to develop entirely new drugs. -

What do ancient viral DNA fragments have to do with schwannoma and meningioma tumours?
Working with bioinformatics expert Dr Robert Belshaw, Dr Sylwia Ammoun discovered that ancient viral DNA fragments embedded in our genome can reactivated in schwannoma and meningioma tumours, driving their growth and survival.
In the lab, the team showed that anti-HIV drugs, could be an effective treatment option.
These findings led to the launch of a phase 1 clinical trial, funded by the Children’s Tumor Foundation and currently overseen by the Plymouth Centre, for patients with NF2-related schwannomatosis who develop schwannomas and meningiomas.
In the news: Clinical trial to repurpose HIV drugs for brain tumour patients
Drugs developed to combat HIV and AIDS are being trialled for the first time in patients with multiple brain tumours.
Scientists at the Brain Tumour Research Centre of Excellence at the University of Plymouth are conducting a clinical trial to see whether using anti-retroviral medications, Ritonavir and Lopinavir, could help people with Neurofibromatosis 2 (NF2). The rare inherited genetic condition causes tumours such as schwannoma (which include acoustic neuroma), ependymoma and meningioma which develop on the membrane surrounding the brain.
The RETREAT clinical trial, funded by the Children’s Tumour Foundation, will expand on research at the Centre which showed that the repurposed drugs reduced tumour growth and survival in tumours.

Theme three: Building world-class resources
The continued growth of the Plymouth BioBank will support the research at the Centre. Developed in close collaboration with clinicians and patients, the Biobank offers researchers a vital resource of patient-linked tumour samples, blood samples, health information and genetic data – enabling world-class research and accelerating the development of treatments that could transform lives.